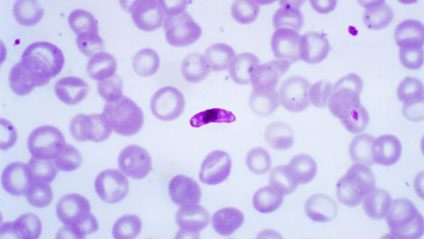
Figura 1 - Striscio di sangue che evidenzia la presenza del parassita Plasmodium falciparum

Il caso della bimba morta di malaria a Trento: Un episodio di malaria in Italia raccontato da Microbiologia Italia.
Indice
Il caso della bimba morta di malaria a Trento
Sofia Zago, bambina di 4 anni originaria di Trento, è morta di malaria negli Ospedali Civili di Brescia lo scorso 4 settembre. Oggi l’attenzione è puntata sulle possibili vie di trasmissione della malattia e sul luogo in cui tale infezione potrebbe essere stata contratta.
Il 13 agosto la piccola aveva avuto già un esordio di diabete mentre era in vacanza a Bibione e, per tale motivo, fu curata prima agli Ospedali di Portogruaro e all’Ospedale di Trento dal 16 al 21 agosto. Il 31 agosto è stata colpita prima da faringite e successivamente da malaria.
A questo punto, il direttore dell’Azienda provinciale dei servizi sanitari (Apss) del Trentino ha ripercorso la storia clinica della bambina. Ha dichiarato che all’ospedale di Trento il 21 agosto erano stati ricoverati due bambini affetti da malaria, contratta in seguito a un viaggio in Burkina Faso. Inoltre ha precisato che Sofia era stata ricoverata in una camera diversa e che non c’erano state trasfusioni di sangue. Ha inoltre affermato che il periodo di latenza potrebbe far pensare al fatto che la malattia fosse stata contratta prima del ricovero. Dalle prime analisi del caso pare che la morte della bambina sia stata causata principalmente da complicanze cerebrali legate alla malattia stessa.
Da chi è causata la malaria?
Vediamo allora qual è l’agente eziologico responsabile della malaria e quali sono le sue vie di trasmissione. La malaria è causata da 5 protozoi parassiti : Plasmodium falciparum, P. vivax, P. ovale, P. malariae e P. knowlesi. Nel caso della piccola Sofia l’agente eziologico responsabile è stato il parassita P. falciparum (il più mortale, figura 1).
Tale parassita (così come gli altri 4 parassiti ad esso collegati) è diffuso attraverso una puntura di una zanzara femmina infetta che si nutre di sangue umano (figura 2). Nel momento in cui la zanzara si alimenta inocula nel sangue dell’ospite le forme immature del parassita, chiamate sporozoiti. Gli sporozoiti vengono trasportati dal sangue al fegato, dove maturano in schizonti che, a loro volta, si moltiplicano in merozoiti. A questo punto i merozoiti fuoriescono dal fegato per essere nuovamente immessi nel sangue ed essere inglobati all’interno degli eritrociti. I merozoiti si riproducono principalmente per via asessuata, ma a volte avviene riproduzione per via sessuata, da cui si sviluppano i gametociti.
I gametociti si accoppiano solo quando entrano nell’intestino di un’altra zanzara che punge una persona infetta e producono gli oocineti. Gli oocineti si “auto-inglobano” nell’intestino della zanzara, a livello del quale maturano in oocisti. Queste ultime si aprono e rilasciano migliaia di sporozoiti che migrano nelle ghiandole salivari dell’insetto pronto ad infettare un altro individuo. A questo punto il ciclo si ripete.

Riguardo alle possibili vie di trasmissione della malaria, sono state formulate tre ipotesi:
Zanzara da bagaglio
La puntura da parte della zanzara è responsabile dell’insorgenza della malattia e della trasmissione del parassita da una persona infetta all’altra. Nel caso della cosiddetta “malaria da bagaglio” o “malaria da aeroporto” gli individui vengono punti nelle vicinanze di aeroporti da zanzare arrivate nei bagagli o negli aerei. Il parassita sopravvive per circa 2 settimane a causa delle condizioni climatiche favorevoli in Italia.
Zanzare autoctone
Secondo una ricerca condotta nel 2009 da Roberto Mori non tutte le zanzare sono capaci di trasmettere P. falciparum, ma nonostante ciò esiste una piccola probabilità che trasmettano ugualmente questo parassita.
Contagio diretto fra malati
La malaria può essere trasmessa anche attraverso le trasfusioni di sangue o siringhe infette.
In conclusione, ancora oggi non si conoscono le modalità di trasmissione del parassita alla bambina, ragion per cui bisognerà attendere ulteriori aggiornamenti da parte delle autorità competenti.
Fonti
- Trento, bambina di 4 anni uccisa dalla malaria
- Gli infettivologi : nel nostro Paese primo caso dal 1997 “Sia la trasmissione via parassiti sia il contatto ematico eventi rarissimi”
- www.britannica.com/science/Plasmodium-falciparum